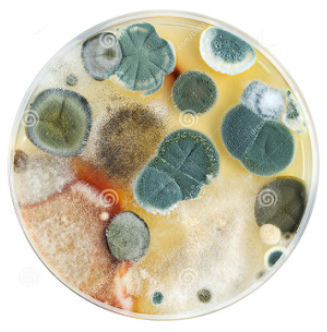

ENGL - ESP
<< >>
Coronawahn 01f-5: Maskenwahn 20.5.2022: Maske=Abgas+Petrischale+Mikroplastik+behinderte Sprachentwicklung+Ausschlag
Die Maske ist eine schlechte Show - maskenfrei lebt sichs gesünder
Titel der Webseite gegen Maskenwahn: Abgas+Petrischale+Mikroplastik+Sprachstörung bei Kindern+Ausschlag [5]
von Michael Palomino (20.5.2022)
| Teilen / share: |
Facebook |
|
Twitter
|
|
|
|
von Michael Palomino, 20.5.2022
Gemäss mehreren Studien ist die Maske eher eine Petrischale als ein schützendes Instrument.
Masken sind voll mit Bakterien und Pilzen, und ausserdem staut sich CO2 in der Lunge.
Masken sind ein Instrument, viel CO2 und Mikroplastik einzuatmen. Und Masken provozieren bei Kleinkindern grosse Sprachfehler.


Hier ist mein Blog mit den Meldungen zum Maskenschaden. Die schweizer Zeitungen und das SF verschweigen diese Fakten, weil der Mossad das verschweigen will - denn dem gehts nur um Börsenkurse mit Maskenverkauf, Testverkauf und Impfverkauf:
http://www.med-etc.com/med/coronavirus/Dt/001fx003-maskenschaden001.html
Titel der Webseite gegen Maskenwahn: Abgas+Petrischale+Mikroplastik+Sprachstörung bei Kindern+Ausschlag [5]
Schlussfolgerung: Maske = schlechte Show
Die Maske ist also nur eine schlechte Show - man sollte die Maske generelle stoppen und verbieten und gesund leben. Wenn alle LehrerInnen und Eltern dies unterschreiben, hat das BAG von Levy und Berset keine Chance mehr.
Gesundheit kommt auch von guter Ernährung.Ich empfehle die Blutgruppenernährung, denn jede Blutgruppe hat ihren eigenen Magentyp und Stoffwechseltyp. Man kann so genau wissen, was für einen gesund und was schädlich ist - die Quote ist 90%.Blutgruppenernährung von Dr. D'Adamo heilt viele "unheilbare" Sachen
Liste 0 - Liste A - Liste B - Liste AB
Ausserdem ist die Ernährung im Sommer anders als im Winter. Im Winter muss man sehr vitaminreiche und Antibiotika-Kost einnehmen (Knoblauch, Ingwer, Zwiebeln, Rettich, Pfefferminze, Eukalyptus, Zitrone in die Suppe, und Grapefruit mit Banane etc.). Im Sommer sind viel mehr Getränke als Kartoffeln und Brot gefragt.
Vor Corona kann man sich nicht mit Masken schützen, sondern eher mit Medikamenten gegen Schlangengifte, denn:
PLUS: Krebszellen
5.7.2022: Maskenwahn provoziert Krebszellen
https://vk.com/mpnatronetc#/mpnatronetc?z=photo346450973_457242231%2Fwall472868156_19748
"Wenn eine Zelle 48 Stunden lang 35% Sauerstoffmangel erhält, verwandelt sie sich in eine Krebszelle."
Dr. Otto H. Warburg (Nobelpreisträger 1931)
Maskenwahn im 4R am 23.7.2022: FFP2-Maske ist nur maximal 75 Minuten erlaubt:
"Gebrauchsdauer für ffp2-maske laut bundesanstalt für arbeitsschutz: maximal 75 Minuten."
https://t.me/oliverjanich/102793
<< >>
| Teilen / share: |
Facebook |
|
Twitter
|
|
|
|
^


